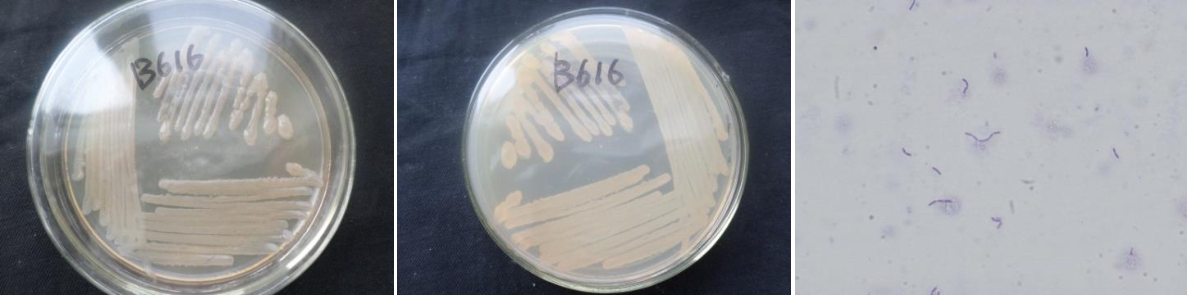

Loading...
| StrainNO | B616 |
| Classification | Bacillus |
| 16s rDNA sequence | AAAAATTGGCGGGGTGCCTATACATGCAAGTCGAGCGGACAGATGGGAGCTTGCTCCCTGATGTTAGCGGCGGACGGGTG AGTAACACGTGGGTAACCTGCCTGTAAGACTGGGATAACTCCGGGAAACCGGGGCTAATACCGGATGCTTGTTTGAACCG CATGGTTCAAACATAAAAGGTGGCTTCGGCTACCACTTACAGATGGACCCGCGGCGCATTAGCTAGTTGGTGAGGTAACG GCTCACCAAGGCAACGATGCGTAGCCGACCTGAGAGGGTGATCGGCCACACTGGGACTGAGACACGGCCCAGACTCCTAC GGGAGGCAGCAGTAGGGAATCTTCCGCAATGGACGAAAGTCTGACGGAGCAACGCCGCGTGAGTGATGAAGGTTTTCGGA TCGTAAAGCTCTGTTGTTAGGGAAGAACAAGTACCGTTCGAATAGGGCGGTACCTTGACGGTACCTAACCAGAAAGCCAC GGCTAACTACGTGCCAGCAGCCGCGGTAATACGTAGGTGGCAAGCGTTGTCCGGAATTATTGGGCGTAAAGGGCTCGCAG GCGGTTTCTTAAGTCTGATGTGAAAGCCCCCGGCTCAACCGGGGAGGGTCATTGGAAACTGGGGAACTTGAGTGCAGAAG AGGAGAGTGGGAATTCCACGTGTAGCGGTGAAATGCGTAGAGATGTGGAGGAACACCAGTGGCGAAGGCGACTCTCTGGT CTGTAACTGACGCTGAGGAGCGAAAGCGTGGGGAGCGAACAGGATTAGATACCCTGGTAGTCCACGCCGTAAACGATGAG TGCTAAGTGTTAGGGGGTTTTCCGCCCCTTAGTGCTGCAGCTAACGCATTAAGGCACTCCGGCCTGGGGGAGTACGGTCG CAAGACTGGAAACTCAAAGGAATTGACGGGGGGCCCGCACAAGCGGTGGGAGCATGTGGGTTTAAATTCGAAGCAACCGT AGGAACCTTTACCAGGGTCTGACATCCTCTGACATCCTAGAAGATAGGACGTCCCCTTCGGGGGGCAAAGTGACAGTTGG TGCATGTTGTCGTCGCCTCGTGCGTGAAGATGGTTGGGTAAGTTCCCGCAACAGCGCAACCTGATCTAGATGCCAAGCATCATTGGCACCTCAGTTACCTGCGGTGACGATGAGGAAGGTGTATACGTCAAATCATCAATGGCCCTTGATGACTGTGGTG CCTACACACCACGTTGCT |
| Strain Morphology Photos | |
| Morphological Description | round;clam white;edge burr;bright;sticky;Rod;no spore |